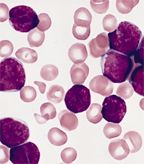

Findings suggesting that obesity substantially impairs the ability of L-asparaginase to kill leukemia cells were reported last month by investigators from The Saban Research Institute, Children’s Hospital Los Angeles.
Findings suggesting that obesity substantially impairs the ability of L-asparaginase to kill leukemia cells were reported online in the journal Cancer Research last month by investigators from the Saban Research Institute, Children’s Hospital Los Angeles. “Obesity is associated with a substantial increase in cancer incidence and mortality worldwide, with an estimated 20% of cancers in the United States due to obesity,” noted lead investigator Steven Mittelman, MD, PhD. Moreover, obesity “appears to decrease survival” from some cancers, including acute lymphoblastic leukemia (ALL). In a previous study, researchers at Children’s Hospital found that obese children diagnosed with high-risk ALL have a 50% greater risk of their disease recurring than their lean counterparts. The mechanisms linking obesity to cancer, however, remain elusive, said Mittelman.
Bone marrow in 3-year-old ALL patient
L-asparaginase, a mainstay of childhood ALL treatment with growing application in adult chemotherapy regimens, acts by hydrolyzing asparagine (ASN) and glutamine (GLN), exploiting the fact that ALL cells are more dependent on these amino acids than are other cells. In the present study, Mittelman and colleagues investigated whether adipocytes, which produce significant quantities of GLN, counteract the effects of L-asparaginase. “[L-asparaginase] efficacy depends on the depletion of ASN and GLN from the leukemia microenvironment,” the authors said. Because adipose tissue is a “major contributor” to the whole-body GLN pool, obesity may impair GLN depletion.
The researchers obtained bone marrow biopsy and blood samples for 19 patients, aged 10 to 18 years, before and during treatment for high-risk leukemia. All patients were treated according to the high-risk Children's Cancer Group (CCG)/Children's Oncology Group (COG) protocol. To test whether obesity might impair L-asparaginase efficacy, the researchers measured plasma levels of amino acids before and after induction chemotherapy, which included a single dose of pegylated L-asparaginase, and examined bone marrow biopsy specimens from four obese and four lean adolescent leukemia patients for expression of ASN synthetase and GLN synthetase. They found no association with altered plasma levels of ASN or GLN, whereas GLN synthetase was markedly increased in bone marrow adipocytes after induction chemotherapy.
Obesity also substantially impaired L-asparaginase efficacy in mice transplanted with syngeneic ALL cells without affecting plasma ASN or GLN levels. In coculture, adipocytes inhibited leukemic cell cytotoxicity induced by L-asparaginase, “and this protection was dependent on glutamine secretion,” reported the investigators. “These findings suggest that adipocytes work in conjunction with other cells of the leukemia microenvironment to protect leukemia cells during [L-asparaginase] treatment.” Thus, strategies to develop alternative L-asparaginase preparations with lower glutaminase activity “may be detrimental to the cytotoxicity of [L-asparaginase] and should be done with caution.”
Understanding and reversing the associations between obesity and leukemia relapse “could prevent significant cancer mortality,” the researchers said. They suggest that new treatment regimens using L-asparaginase focus on the effectiveness of the drug on the cancer microenvironment, as well as on suppression of plasma ASN and GLN levels. “Adipose tissue may have a key role to maintain a leukemia cell population during [L-asparaginase] treatment,” they concluded. “Given the rising prevalence of obesity worldwide, pharmacologic strategies aimed to modulate adipocyte effects on malignant cells might become important in cancer treatment.”
“Our immediate goal is to develop strategies to counteract these effects of fat cells and obesity,” said Ehsan Ehsanipour, first author on the Cancer Research paper. “For example, forms of [L-asparaginase] which break down glutamine faster might have a better effect in obese children.” Other projected clinical studies include testing whether diet or exercise could help the prognosis of obese pediatric patients with leukemia.
“This research really shines a light on how cancer cells avoid chemotherapy,” said Brent Polk, MD, director of the Saban Research Institute. “As childhood obesity has become a global challenge, our understanding of how to beat cancer in children is advanced by these important findings.”